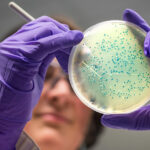

Le lait sans lactose est tout aussi bienfaisant pour la santé que le lait non délactosé : Il conserve ses qualités nutritionnelles. Il est très digeste. Il permet aux personnes intolérantes au lactose de se libérer de nombreux symptômes liés à cette intolérance, à savoir : flatulences, spasmes intestinaux, diarrhées.
Ainsi, Quels sont les méfaits du lactose ?
Le lactose mal digéré peut dans certains cas provoquer des troubles très divers, entre trente minutes et deux heures après l’ingestion: ballonnements, diarrhées, flatulences, nausées, crampes et douleurs abdominales, vomissements, borborygmes « Les symptômes dépendent de la quantité de lactose et de la sévérité de l’
Est-ce que le lactose est bon pour la santé ? Selon un avis de l’Autorité européenne des sécurité des aliments, ils peuvent malgré tout tolérer une prise de 12 g de lactose (soit 250 ml de lait) sans montrer de symptômes, et des quantités supérieures si la consommation de produits laitiers est répartie dans la journée.
En Bref, Quel est le meilleur lait sans lactose ?
La boisson de soja représente le meilleur substitut au lait traditionnel car il contient sensiblement les mêmes quantités de calcium, de vitamine D et de protéines. Par contre, les boissons d’amandes ou de riz sont moins nourrissantes car elles contiennent très peu de protéines.
Et, Pourquoi manger sans lactose ? Le premier bienfait à l’adoption d’un régime sans lactose est la diminution des troubles digestifs. En effet, les personnes concernées justifient leur intolérance au lactose par des ballonnements, des crampes à l’estomac, des nausées voire des diarrhées.
Quels sont les symptômes de l’intolérance au lactose ?
L’ intolérance au lactose est un problème de digestion du sucre contenu dans le lait et ses produits dérivés.
Il s’agit de symptômes digestifs :
- excès de gaz intestinaux et gargouillis,
- sensation de ballonnement abdominal,
- crampes et douleurs abdominales,
- diarrhée.
Pourquoi les produits laitiers sont mauvais pour la santé ?
Ils sont pointés du doigt comme étant la source de maladies dégénératives. La consommation de produits laitiers animaux fait le lit des maladies auto-immunes telles que : Maladie de Crohn. Maladie Coeliaque.
Comment savoir si l’on est intolérant au lactose ?
Symptômes de l’ intolérance au lactose
- Flatulences ;
- Douleurs abdominales ;
- Diarrhées ;
- Ballonnements.
- Crampes abdominales,
- Nausées et/ou vomissements ;
Est-ce que le lactose fait grossir ?
Le gluten et le lactose pourraient, en provoquant des troubles digestifs chez un grand nombre d’individus intolérants, favoriser les rondeurs et les kilos en trop. Leur mauvaise assimilation fait ballonner, donc gonfler le ventre.
Pourquoi le lait n’est pas bon pour les adultes ?
Second argument avancé : selon certaines études, la consommation de lait pourrait avoir des effets négatifs sur la santé des adultes. Certains l’accusent d’augmenter le risque de cancer de la prostate quand d’autres défendent ses bénéfices contre l’ostéoporose, le diabète de type II, l’hypertension et l’obésité.
Quel est le lait qui contient le moins de lactose ?
Les fromages de brebis et de chèvre (bûche, brique, fromage frais, crottin) renferment également peu de lactose et sont généralement bien tolérés, de même que le fromage blanc de brebis.
Quel lait faible en lactose ?
4 produits laitiers naturellement pauvres en lactose
- Le beurre.
- Le fromage à pâte dure.
- Le caillage et l’égouttage du lait permettent d’éliminer une grande partie du lactose .
- Le yaourt.
- Le Kefir.
Quelle est la différence entre le lactose et la lactase ?
Le lactose nécessite une enzyme, la lactase, pour être digéré. La lactase, normalement produite par l’intestin, décompose le lactose provenant de l’alimentation en deux autres sucres (glucose et galactose), qui peuvent être facilement absorbés par l’intestin.
C’est quoi un régime sans lactose ?
Suivre un régime sans lactose consiste à éliminer de son alimentation le lait, les produits laitiers et leurs dérivés, de manière plus ou moins rigoureuse en fonction de la tolérance digestive.
Pourquoi le lactose fait grossir ?
Le gluten et le lactose pourraient, en provoquant des troubles digestifs chez un grand nombre d’individus intolérants, favoriser les rondeurs et les kilos en trop. Leur mauvaise assimilation fait ballonner, donc gonfler le ventre.
Comment remplacer le lactose ?
les boissons végétales pour remplacer le lait : “lait végétal” d’amande, d’avoine, d’épeautre, de riz, de châtaigne, de soja, de noisette, etc. les crème végétale pour remplacer la crème fraîche et la crème liquide: crème d’amande, crème de riz, crème de soja, crème de coco.
Comment soulager les symptômes d’une intolérance au lactose ?
Mangez du fromage! Les fromages à pâte dure comme le Cheddar ou le Parmesan ont naturellement une teneur plus faible en lactose, ce qui les rend plus faciles à digérer. Consommez du yogourt et des boissons à base de yogourt comme le kéfir. Ils contiennent de bonnes bactéries vivantes qui aident à décomposer le lactose.
Où faire le test pour intolérance au lactose ?
Ce test peut être fait en ambulatoire chez un gastro-entérologue ou dans une unité d’exploration fonctionnelle de gastro-entérologie d’un hôpital et dure environ 4 heures (mesure de la quantité d’hydrogène expiré toutes les 30 minutes pendant 4 heures).
Comment combattre l’intolérance au lactose ?
Une gélule de Lactolérance est essentiellement composé de lactase. En utilisant Lactolérance, vous compensez le manque de lactase dans votre tube digestif ; vous pouvez ainsi digérer le lactose comme les personnes tolérantes.
Pourquoi les produits laitiers sont inflammatoires ?
Les produits laitiers sont souvent décriés pour leur teneur en acides gras saturés susceptibles de favoriser l’inflammation. À ce jour, l’impact de ces produits sur l’inflammation postprandiale dépendrait avant tout de la quantité consommée, et ce au même titre que d’autres sources de lipides.
Pourquoi le lait est mauvais pour les adultes ?
Second argument avancé : selon certaines études, la consommation de lait pourrait avoir des effets négatifs sur la santé des adultes. Certains l’accusent d’augmenter le risque de cancer de la prostate quand d’autres défendent ses bénéfices contre l’ostéoporose, le diabète de type II, l’hypertension et l’obésité.
Pourquoi le fromage est mauvais pour la santé ?
Plus un fromage a une teneur élevée en matières grasses, plus il contient d’acides gras saturés, reconnus pour augmenter le cholestérol sanguin.
Quel test pour savoir si on est allergique au lactose ?
Test de tolérance au lactose : après ingestion d’une quantité déterminé de lactose, la quantité de glucose dans le sang (glycémie) est mesurée par une prise de sang. Breath Hydrogen Test : mesure la quantité d’hydrogène expiré par le patient après ingestion de lactose.
Comment savoir si on a une intolérance ?
Maux de ventre chroniques, nausées régulières, maux de tête à répétition, problèmes de peau… autant de symptômes qui peuvent laisser supposer une intolérance à certains aliments.